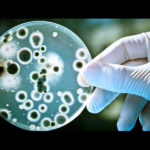

বেঙ্গল কেমিক্যালসের ঠিকা কর্মীদের অনিশ্চিত ভবিষ্যৎ
১৪ দিন ধরে চলছে বেঙ্গল কেমিক্যালসের ঠিকে কর্মচারীদের বিক্ষোভ। এক দিকে কেন্দ্রীয় সরকার নীতি আয়োগের বক্তব্য অনুসারে বেসরকারি হাতে যেতে চলেছে এই ঐতিহ্যশালী সংস্থাএবং অন্য দিকে সংস্থার কর্তৃপক্ষ বাইরের পথ দেখাচ্ছে ৪৫ জন ঠিকে শ্রমিককে। গ্রাউন্ডজিরোর প্রতিবেদন। বেঙ্গল কেমিক্যালস-এর বেসরকারিকরণের কারণে চাকরি হারাবেন বেশ কিছু শ্রমিক। বেসরকারি সংস্থার হাতে তুলে দেওয়ার ফলস্বরূপ ভিআরস […]